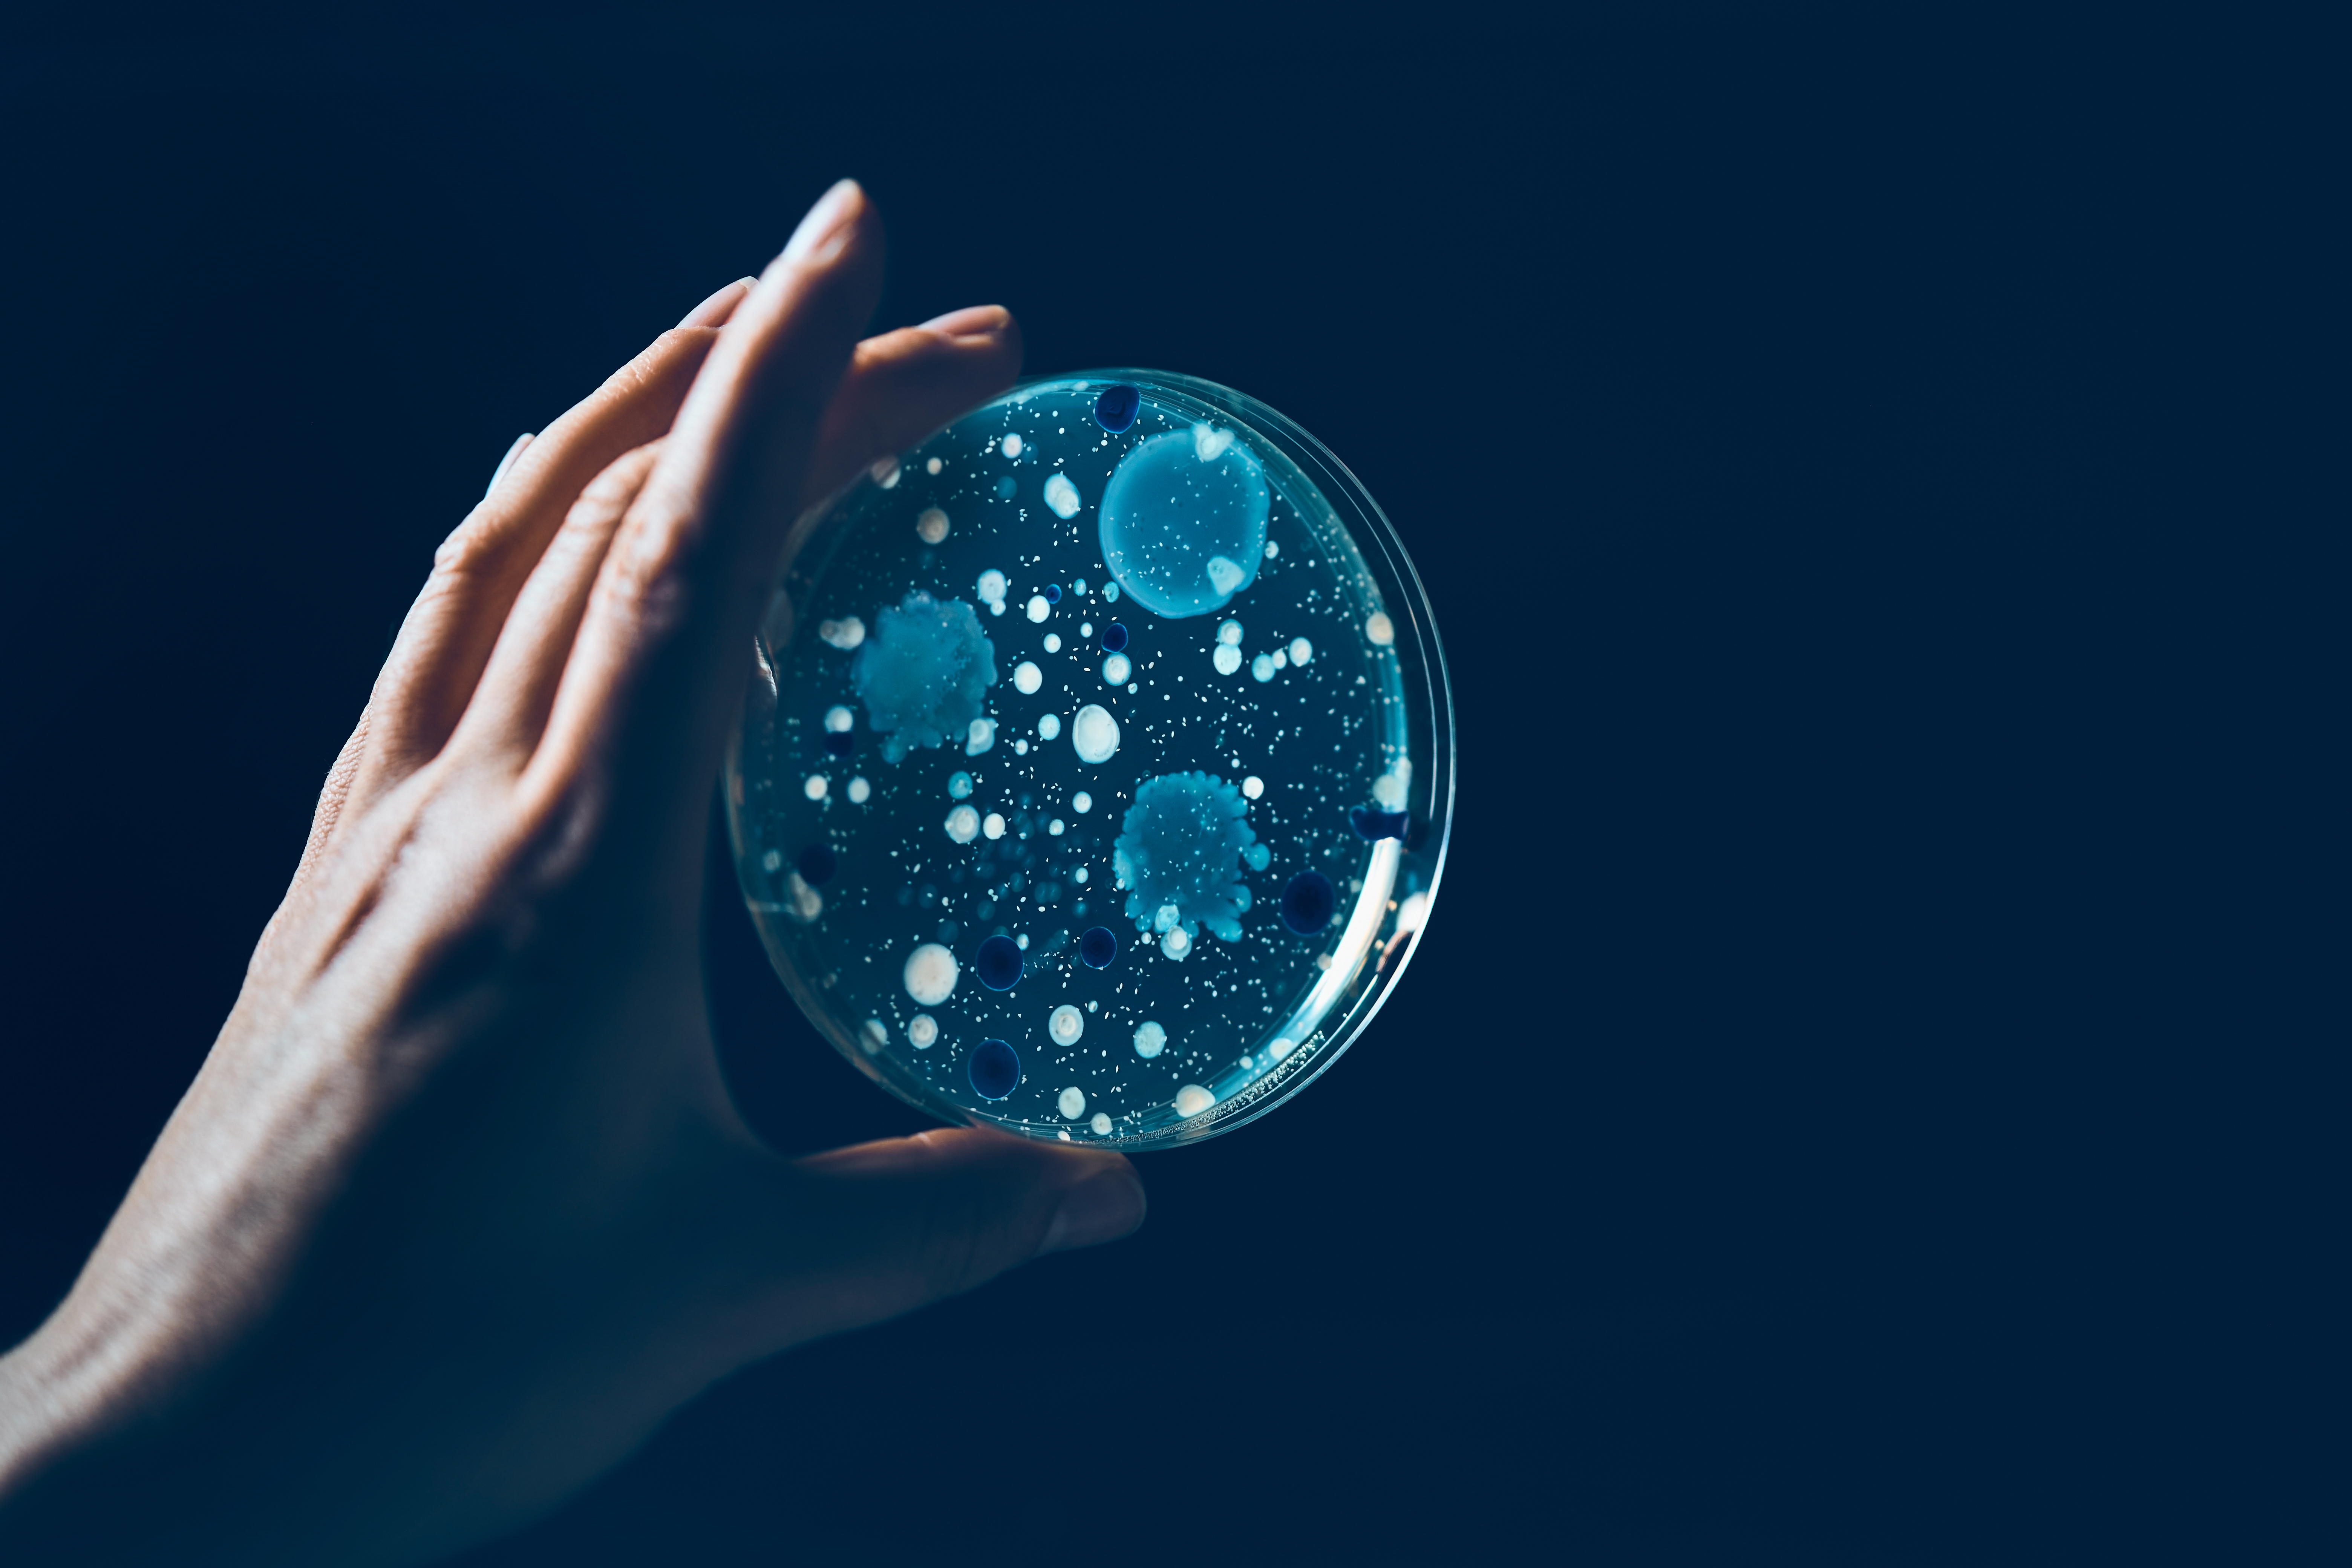
_MG_2149.jpg

ValdresLab har lenge analysert vannprøver fra melkerom, og i den anledning tilbudt henting av prøver som en tilleggsservice til våre kunder. Det er medlemmer av Nord-Aurdal Lions som reiser rundt og henter prøvene for oss. Prøvehentingen organiseres slik at vi rekker å analyse alle prøver innen 12 timer etter prøveuttak. Dette tilfredsstiller kravet til analysestartstart i standarden som Drikkevannsforskriften krever skal benyttes for å analysere kimtall. KSL standarden for melk henviser til Drikkevannsforskriften som lovverk under analyse av vann fra melkerom.
Kunder som er påmeldte ordningen vil tidlig hver vår motta informasjon om når stølsprøverunden er, og når gårdsprøverunden er. På denne måten er samtlige kunder informert, og oppfordres på samme tid til å informere laboratoriet om eventuelle endringer innen gitt tidsfrist. Ved ønske om nærmere informasjon om ordningen, ta kontakt med oss per telefon eller e-post.
Dersom det er ønskelig å levere prøven selv, så er det også mulig. Ta i så tilfelle kontakt for nærmere informasjon.
Foto: Cathrine Dokken Belsheim